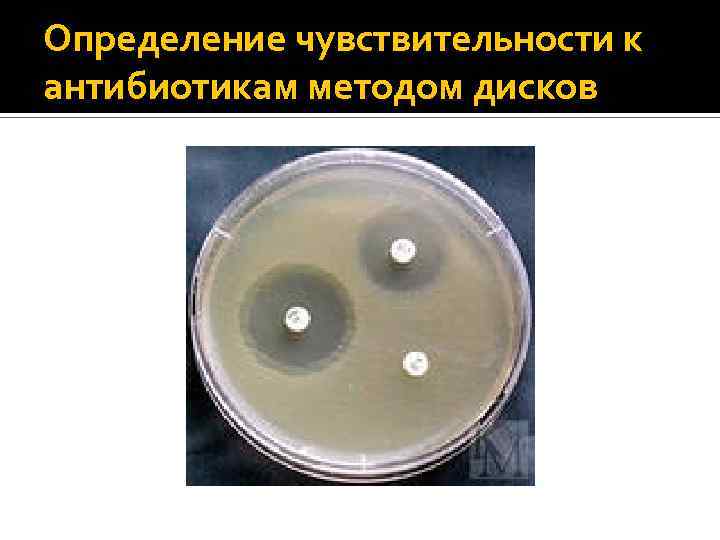

Методы определения чувствительности бактерий к антибиотикам схема
Обновлено: 24.05.2025 - 30 фото
- Творческий проект по технологии на тему торт медовик
- Требование по независимой гарантии по 44 фз образец
- Проект по окружающему миру 2 класс страна бразилия